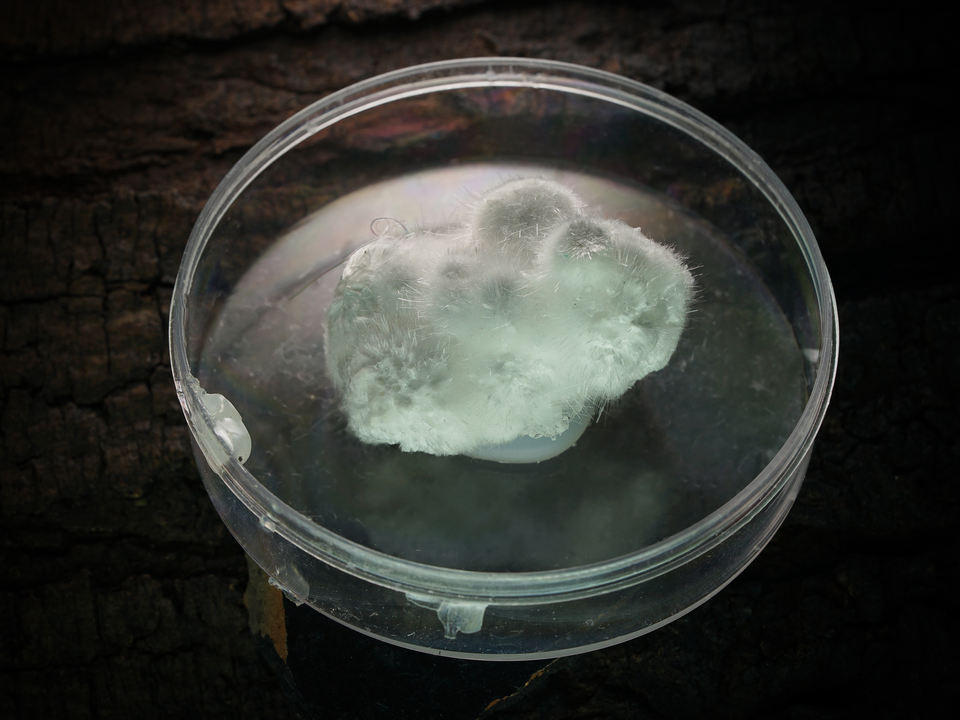

คุณลักษณะ
โอคีไนท์วัสดุพลอย
สำหรับการทำเครื่องประดับการใช้
Rajasthan, Indiaสถานที่กำเนิด
รูปร่างแฟนซีรูปร่างอัญมณี
ไม่มีประเภท รับรอง
ZAHARA GEMSชื่อแบรนด์
หมายเลขรุ่น:NA
ประเภทเพชรพลอย:โดยธรรมชาติ
สีพลอย:สีขาว
ขนาดเพชรพลอย:กำหนดเอง
น้ำหนักเพชรพลอย:กำหนดเอง
ทรีทเม้นประยุกต์:โดยธรรมชาติ
เทคนิคพิเศษแสง:กำหนดเอง
ความสูงของรายการ:กำหนดเอง
หลุมเส้นผ่าศูนย์กลาง:กำหนดเอง
การใช้งาน:อุปกรณ์เครื่องประดับ DIY
เวลาจัดส่ง:5-7วันทำการ
ม็อค:10กะรัต
วัสดุ:วัสดุอัญมณีธรรมชาติ
รูปร่าง:แฟนซี
ชื่อผลิตภัณฑ์:ควอตซ์
สี:สีขาว
คุณภาพ:เกรด AAA
แอปพลิเคชัน:เครื่องประดับสร้อยคอจี้แหวน
ตัด:แฟนซี
ขนาด:ประมาณ 20มม.
คุณสมบัติ:Mateiral ธรรมชาติ
อัญมณี:โอคีไนท์
การชำระเงิน:เพย์พาล/เวสเทิร์นยูเนี่ยน/100% TT
ชื่ออัญมณี:โอคีไนท์
ขายหน่วย:รายการเดียว










